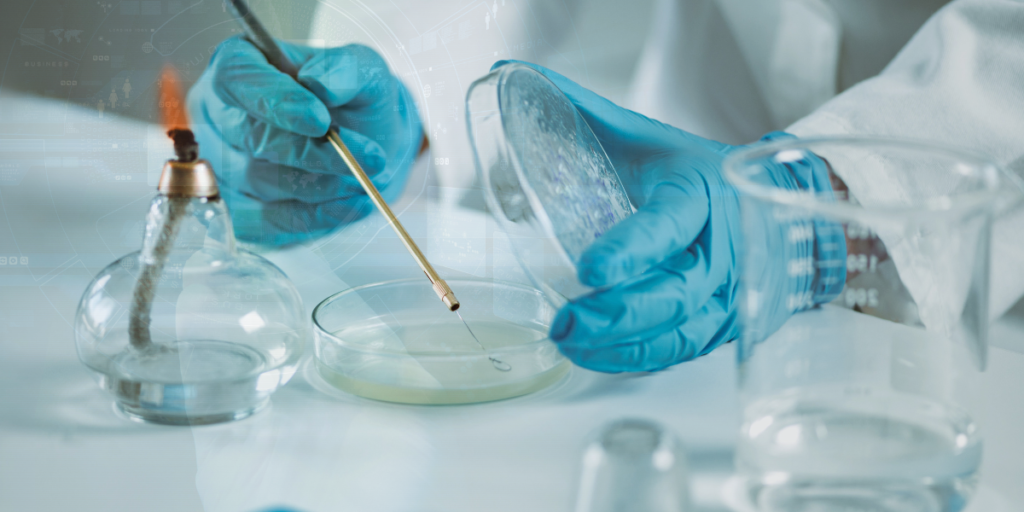

Microbiology
Microbiology
- Introduction to Laboratory Practices
- Overview of Good Manufacturing Practices (GMP).
- General safety instructions for microbiology labs.
- Instrumentation and Equipment Handling
Proper usage and maintenance of laboratory instruments, including:
- Autoclave
- Laminar Air Flow System
- Incubator/Shaker
- Hot Air Oven
- Microscope and other essential tools etc.,
- Media Preparation and Sterilization
- Preparation of solid and liquid media.
- Sterilization techniques for microbial culture media.
- Microbial Isolation and Culturing
- Techniques for isolating and culturing microbes from soil samples.
- Screening of microorganisms for specific traits.
- Staining Techniques
- Basic and advanced staining methods, including:
- Gram Staining
- Endospore Staining
- Antibiotic Sensitivity Testing
- Methods to assess microbial sensitivity to antibiotics.
- Enzyme-Producing Microbes
- Isolation and identification of microorganisms producing enzymes of interest.
- Antibiotic Resistance Studies
- Isolation of antibiotic-resistant (MDR) microbes from soil samples.
- Advanced Techniques and Applications
- Exploring additional microbiological techniques and experiments, progressing from basic to advanced levels.
Training/Internship/Dissertation/Upskilling Module Fee Structure: 2025
7-Day Module (Microbial Basics)
This short-term practical module introduces students to core microbiology skills like media preparation, sterilization, aseptic techniques, environmental sampling, streaking, colony isolation, and microbial growth curve plotting. Ideal for beginners seeking foundational lab skills.
Lecture | Hands on Activities |
Nutrient media: components and types (agar vs broth) |
|
Importance of pH, energy sources, and solidifying agents |
|
Sterilization techniques: autoclaving, filtration |
|
Aseptic techniques and their importance, Types of plating: pour plate, spread plate, Microbial diversity in soil, water, and air |
|
Purpose of pure culture and isolated colonies, Different streaking patterns (T-streak, quadrant method), Subculturing and maintenance of cultures |
|
Concept of serial dilution and CFU calculation, Importance in estimating bacterial concentration, Dilution factor and log reduction |
|
Phases of microbial growth: lag, log, stationary, death, Factors affecting growth: temperature, pH, nutrients, OD measurement at 600 nm |
|
15-Day Module (Microbial Growth & Assay Skills)
Builds on basics and includes microbial growth under different pH and temperature conditions
Lecture | Hands on Activities |
Introduction to lab safety, equipment (PPE, autoclave, laminar flow) | Lab tour, PPE demo, autoclave operation, glassware cleaning |
Nutrient media: broth vs agar, role of pH and nutrients | Media prep (nutrient agar, broth), pH adjustment, autoclaving |
Sterilization methods: autoclaving, filtration, chemical | Pouring sterile plates, filtration setup |
Aseptic techniques, environmental sampling | Pour/spread plating soil/water samples, incubation |
Pure culture, colony morphology, streaking techniques | T-streak & quadrant method on nutrient agar, slant prep |
Serial dilution, CFU calculation, dilution factor logic | Perform ten-fold dilutions, plating, colony counting |
Microbial growth phases (lag/log/stationary/death), OD measurement | Inoculate broth, measure OD600 at intervals, plot growth curve |
Effect of pH on microbial growth: pH as a limiting factor | Inoculate same strain in broth at different pH (e.g., 4, 7, 9), OD600 reading |
Effect of temperature on microbial growth: thermal limits of bacteria | Incubate cultures at different temps (e.g., 25°C, 37°C, 45°C), measure growth |
Concept of antibiotic resistance, introduction to sensitivity testing | Prepare nutrient agar, place antibiotic discs, incubate (Kirby-Bauer method) |
Zone of inhibition: how it reflects antibiotic effectiveness | Measure zones using a ruler, record and interpret results |
Introduction to staining techniques, bacterial cell structure | Perform Gram staining, observe under microscope, classify organisms |
Review of fermentation principles, importance in enzyme production | Basic fermentation setup with glucose broth, observe changes |
Data recording & basic statistics: mean, range, graphing | Enter growth & sensitivity data, create growth curves and bar graphs |
Final assessment, recap of concepts, Q&A, project feedback | Report submission, peer discussion, certificate distribution |
30-Day Module (Growth + Enzyme Studies)
A full-cycle hands-on program covering microbial growth, enzyme production, and analysis under various pH and temperature conditions. Includes growth curve plotting, OD600 measurement, enzyme activity assays, Gram staining, and antimicrobial resistance testing. Final report writing and presentation included.
Lecture | Hands on Activities |
Lab safety, equipment intro, glassware, PPE | Lab tour, autoclave demo, cleaning |
Media types, pH role, nutrients | Prepare nutrient agar & broth, pH adjustment |
Sterilization methods: heat, chemical, filtration | Plate pouring, media sterilization |
Aseptic techniques, contamination control | Laminar flow work, demo inoculation |
Colony morphology, isolation methods | Spread/pour plate of soil samples |
Test 1 | Quiz + review media prep and aseptic steps |
| |
Pure culture techniques | T-streak, quadrant streak, isolate colonies |
Serial dilution, CFU logic | Perform dilutions, plating |
Growth curve theory (lag/log/stationary) | Inoculate broth, start OD600 monitoring |
Generation time, plotting curves | Continue OD600 readings, graphing |
Gram staining: principle, cell wall types | Gram stain + microscopy |
Test 2: CFU + Growth Curve + Staining Quiz | Evaluate plating, Gram stain slides |
| |
pH effect on microbial growth | Inoculate broths at pH 4, 7, 9 |
Data collection & curve plotting | OD600 at intervals, plot growth vs pH |
Intro to enzyme production | Prep starch/casein media, inoculate cultures |
pH effect on enzyme production | Use pH-varied broth to produce enzymes |
Enzyme assay intro (DNS/Iodine) | Centrifuge, collect supernatants |
Test 3: Growth vs pH + Enzyme Theory | Spot test + check enzyme assay prep |
— | OFF |
| |
Enzyme activity measurement | Perform DNS/Iodine assay, OD reading |
Plot enzyme activity vs pH | Graph and interpret |
Temp effect on growth | Inoculate broth at 30°C, 37°C, 45°C |
OD reading, growth vs temperature | OD600 readings and plotting |
REPORT WRITING |
60-Day Module (Advanced + UV Mutagenesis)
This advanced project-based training includes all foundational skills plus an in-depth study of UV mutagenesis and strain improvement. Students screen UV-treated colonies for enhanced enzyme production and compare enzyme activity across wild and mutant strains under different pH and temperature. Includes full report compilation and scientific presentation training.
Lecture | Hands on Activities |
Lab safety, equipment intro, PPE | Lab tour, PPE, glassware cleaning |
Media types, agar vs broth, nutrients | Prepare media, adjust pH, autoclaving |
Sterilization methods | Media pouring, filtration |
Aseptic techniques | Laminar work, demo inoculation |
Sampling from soil/water | Spread/pour plates |
Colony morphology | Observe colonies, record traits |
Isolation techniques | T-streak, quadrant streak |
Serial dilution, CFU logic | 10-fold dilutions, plate counts |
Growth curve intro | Inoculate broth, start OD600 tracking |
Generation time | Measure OD, plot growth curve |
Gram Staining + Antibiotic Sensitivity | |
Gram staining principle | Gram stain and microscopy |
Gram +ve vs –ve | Record observations |
Antibiotic resistance | Disc diffusion method |
Zone of inhibition | Measure and record zones |
Mini test + data review | Practical check, recap basics |
Effect of pH on Growth & Enzyme | |
Effect of pH on growth | Inoculate broths at pH 4, 6, 7, 8, 9 |
OD readings | Measure growth over time |
Plot: Growth vs pH | Data logging and graphing |
Enzyme production intro | Prep starch/casein broth |
Enzyme production at diff pH | Inoculate cultures in pH-varied media |
Collect supernatant | Centrifuge cultures |
DNS/Iodine assay methods | Perform assay, measure OD |
Plot: Enzyme activity vs pH | Graphing and analysis |
Enzyme optimization discussion | Evaluate pH range for activity |
Short test + review | Practical + theory test |
UV Mutagenesis | |
UV light as mutagen | UV light safety briefing |
DNA damage by UV | Dose-response logic |
Lawn culture prep | Spread wild-type strain on plates |
UV exposure (1–5 min, ~30 cm) | Half-plate covered as control |
Incubation & survivor selection | Select visible colonies |
Theory: Screening mutants | Enzyme-linked trait selection |
Screening on starch/casein agar | Streak selected colonies |
Incubate and observe clearance zones | Compare with wild-type control |
Inoculum preparation | Broth cultures of top mutants |
Fermentation basics | Equal inoculum into fermentation medium |
Growth of wild vs mutant | Constant pH/temp for both |
Harvest & centrifugation | Collect supernatants |
Enzyme assay (DNS/Iodine) | Measure OD/zone diameter |
Data plotting | Compare mutant vs wild-type |
Discussion: strain improvement | Identify best-producing mutant |
Temperature Effect on Growth & Enzyme | |
Temperature as growth factor | Inoculate cultures at 25, 30, 37, 45°C |
OD readings over time | Record temp-growth pattern |
Plot: Growth vs temperature | Graph interpretation |
Enzyme production at different temps | Inoculate media, incubate at varied temps |
Harvest and centrifuge | Collect enzyme-rich supernatants |
Assay method review | Prepare DNS/Iodine reagents |
Measure enzyme activity | OD reading |
Plot: Enzyme activity vs temp | Final graph comparison |
Comparison: optimal conditions | Identify peak performance temp |
Test series + discussion | Evaluate understanding |
Data Compilation & Project Report | |
Organize data: CFU, OD, assay results | |
Graph cleanup: pH, temp, mutagenesis | |
Draft: Introduction, Objective | |
Draft: Methods & Observations | |
Draft: Results & Discussion | |
Prepare charts, tables, legends | |
Review and correction | |
Finalize individual/group reports | |
Student presentations/poster prep | |
Final presentation day + Certificate distribution |